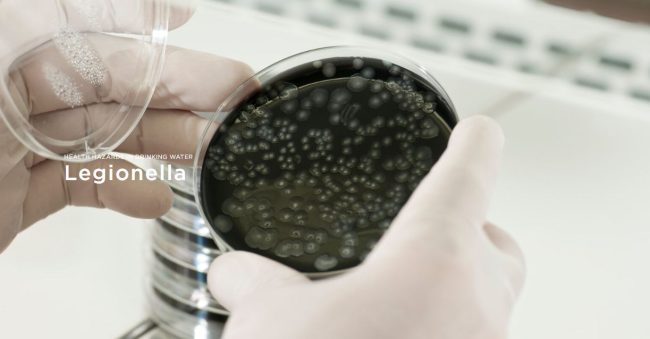
1 (1)

Legionela – Opasnosti po zdravlje u vodi za piće
su prirodni stanovnici naših tla i izvora pitke vode ne uklanjaju ih vodovodi ulaze u domaći vodovodni sistem u veoma malim koncentracijama i pronađu idealne uslove za razmnožavanje u vodovodnim cevima zgrada. Koliko je opasna legionela? Institut Robert Koh izbrojao je približno 1.281 prijavljeni slučaj* legionarske bolesti u Nemačkoj 2020. Broj neprijavljenih slučajeva je verovatno…